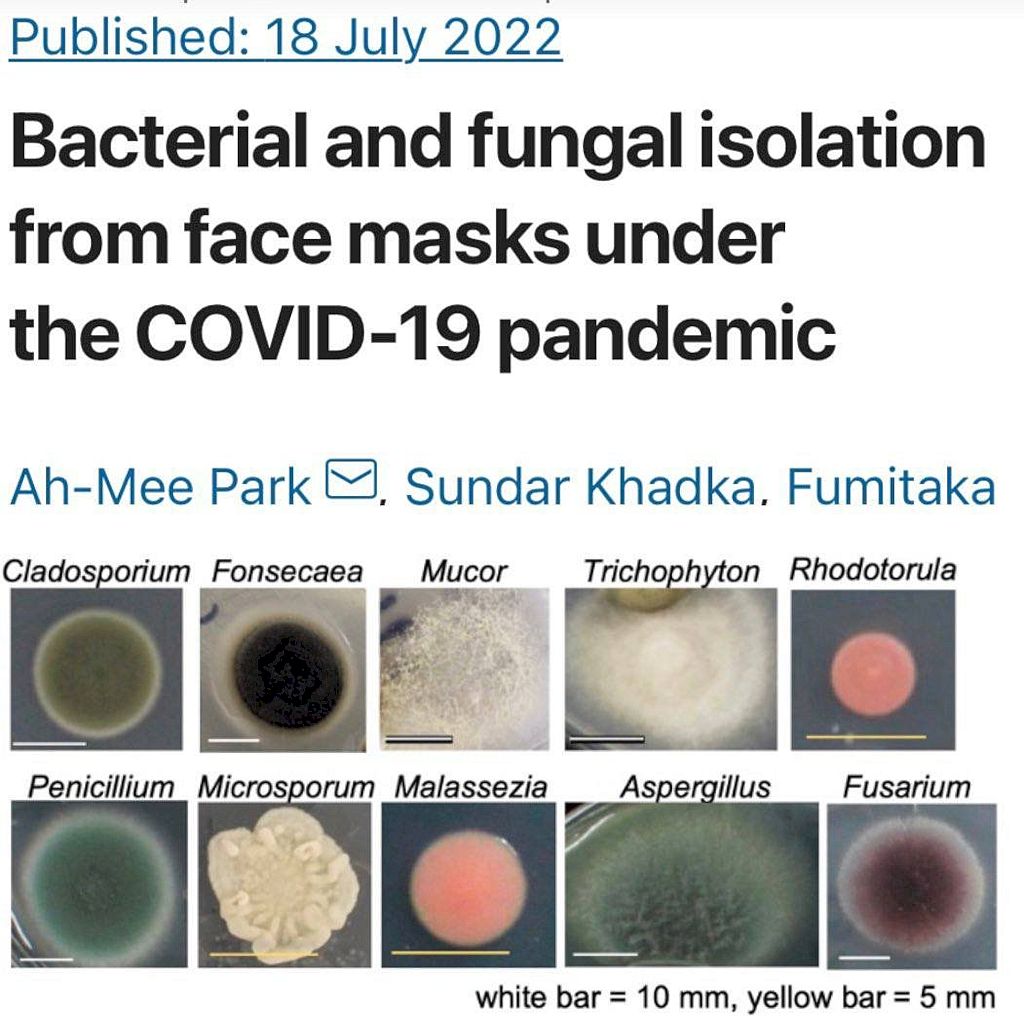
Der wahre Grund für die Maskenpflicht in der Pandemie

Masken haben während der Pandemie funktioniert, aber nicht in der Art und Weise, wie sie kommuniziert wurden. Sie wurden als soziales Konditionierungsinstrument eingesetzt, um alle an eine angeblich tödliche Pandemie zu erinnern. Sie waren eine tägliche Erinnerung an einen unsichtbaren Feind, der sich als weit weniger tödlich erwies als behauptet.
Schon während der Spanischen Grippe wurde behauptet, dass Masken die Ansteckungsgefahr um 99 % verringern würden. Studien deuten jedoch darauf hin, dass das lange Tragen von Masken bereits 1918 bakterielle Lungenentzündungen verursachte.
Dies wirft eine Frage auf, die selbst Sherlock Holmes überraschen könnte: Wenn Masken einst als so wirksam wie ein Sieb in einem U-Boot galten, warum dann der plötzliche Umschwung? Liegt die Wahrheit in der Vergangenheit oder spielen wir nur ein globales Versteckspiel?
Die Logik der Übertragungsprävention war extrem zufällig und politischer Natur. Ist das Virus in der Lage, zwischen angeblich solidarischen Bürgern und sogenannten Coronaleugern zu unterscheiden? Oder kann es erkennen, ob man in einem Restaurant sitzt oder auf die Toilette geht?
Selbst die WHO war ursprünglich gegen Masken bis Mai 2020. Plötzlich änderten sie ihre Haltung ohne angemessene wissenschaftliche Untersuchung.
"Our guidance also explains how to use a mask safely.
People can potentially infect themselves if they use contaminated hands to adjust a mask, or to repeatedly take it off and put it on, without cleaning hands in between"-@DrTedros #COVID19 pic.twitter.com/YO5eUQWdWv
— World Health Organization (WHO) (@WHO) June 5, 2020
In einer Welt, in der Masken als so wirksam wie ein Hafersack galten, kam das Jahr 2020 zu einer überraschenden Wendung. Trotz eines historischen Konsenses, der Masken als nutzlos einstufte, änderten die Experten plötzlich ihre Meinung. Man fragt sich, was diese dramatische Veränderung ausgelöst hat. Diese «Die Maskenrevolution» beschränkte sich nicht auf eine einzige Region. Sie erstreckte sich über Kontinente. Vor allem der brasilianische Schützling von Pfizer Atila Iamarino, der einst Masken verachtete, hat sich rechtzeitig um 180 Grad gedreht, um im Gleichschritt mit der grossen Parade von Pfizer zu marschieren.
Aber halt, da ist noch mehr. Was hat es mit dem plötzlichen Schweigen der normalerweise gesprächigen wissenschaftlichen Welt auf sich? Warum machen sie bei Massnahmen mit, die nicht viel Sinn machen? Es ist, als hätte jemand die Stummschalttaste bei all unseren freimütigen Experten gedrückt.
Die Puppenspieler dieses Schweigens? Die Global Players. Zum Beispiel der deutsche Virologe Christian Drosten, der für den betrügerischen Covid PCR-Test verantwortlich ist. Seine Aussage war einfach: Zweifel an allen, die es wagen, das offizielle Narrativ in Frage zu stellen.
Und dann gibt es noch Gesundheitsbeamte wie Dr. Theresa Tam, die die Grenzen auf ein neues Niveau heben. Sie predigen Masken selbst in den intimsten Momenten und befürworten Glory Holes als pandemiesichere Lösung für fleischliche Begierden.
Auch heute noch hausieren «Gelehrte» wie Joseph Allen von der Harvard T.H. Chan School of Public Health mit ihren Masken-, Paxlovid- und Impfstoffnarrativen und versuchen, jeden zum Schweigen zu bringen, der mutig genug ist, empirische Gegenargumente vorzubringen.
Dann gibt es noch Journalisten wie Dr. Lucky Tran von The Guardian die die Menschen auffordern, die Ergebnisse des Cochrane-Reviews zur Wirksamkeit von Masken zu ignorieren. Fehlinformationen werden weiterhin verbreitet, obwohl die Regierungen auf der ganzen Welt langsam zur Wahrheit stehen.
Und vergessen wir nicht die professoralen Spitzel wie Amir Attaran die Nicht-Maskenträger verpfeifen. Ich verachte diese Art von Möchtegern-Gestapo. Sie sollten zur Rechenschaft gezogen werden und Konsequenzen für ihr Verhalten tragen.
Auch Infaulenzer Influencer wie BrooklynDad_Defiant! der über keinerlei Fachwissen verfügt, fordern, dass jeder zwangsweise eine Maske tragen sollte. Er ging sogar so weit, dass er Donald Trump als Mörder bezeichnete, weil er das Maskentragen der persönlichen Entscheidung überlässt.
Aber das wahre Grauen war noch nicht erreicht. Unschuldige Kinder, die von Erwachsenen, die es eigentlich besser wissen müssten, wurden manipuliert und in ein schlechtes Licht gerückt. Viele werden ein Leben lang mit dem Trauma zu kämpfen haben, das ihnen in ihren prägenden Jahren zugefügt wurde.
Den Menschen wurde vorgegaukelt, dass die Masken wirklich funktionieren würden. Seit April/Mai 2020 hat die ausgewogene und sachliche Berichterstattung in den Medien Pause gemacht. Die gesellschaftlichen Auswirkungen? Katastrophal, um es vorsichtig auszudrücken.
Das Ironische daran? Die Masken hatten keinerlei Einfluss auf die Infektionsraten, wie diese Grafik deutlich zeigt:
- North Dakota: Abriegelungen und Maskenpflicht
- South Dakota: Freie Gesellschaft
Selbst wissenschaftliche Meta-Analysen legten nahe, dass Masken mehr Schaden als Nutzen anrichten. Diese Daten waren öffentlich zugänglich, aber Big Tech und die Mainstream-Medien drückten ein Auge zu, sprich zensierten, wie es dies in der Welt vorher noch nicht gegeben hat und die Politiker folgten diesem Beispiel.
Hast du schon einmal über die physiologischen und psychologischen Auswirkungen von Masken nachgedacht? Selbstkontamination, Immunsuppression, chronischer Stress und Depression. Ein hoher Cortisolspiegel führt zu vorzeitiger Sterblichkeit. Und doch wurde diese «Behandlung» verschrieben!
Die sozialen Medien wurden zu den Wächtern der «Wahrheit». Wer es wagte, Masken in Frage zu stellen oder Links zu von Experten begutachteten Meta-Analysen zu posten, wird zensiert, blockiert und gelöscht. Twitter, Facebook (Meta), Youtube, LinkedIn et al. fahren fort, die Wahrheit zu verschweigen, die täglich Tausende hätte retten können. Die Haltung der Regierung Biden? Wer es wagt, «Fehlinformationen» über Masken, Ivermectin, Vitamin D oder Covid-Impfstoffe zu verbreiten, ist ein Blockierung nicht genug. Sie sollten von allen Social-Media-Plattformen verbannt werden.
Sozialistische Lehrer wie Marcel Hopp machten sich einen Spass daraus, Schüler mit Masken und PCR-Tests zu quälen und prahlten sogar im Internet damit. Bildung oder Tyrannei?
Eine Studie in Nature bestätigt eine seit langem bekannte Tatsache: Masken beherbergen krankheitserregende Bakterien und Pilze. Längerer Gebrauch bedeutet mehr Pilze, eine Petrischale, die an deinem Gesicht klebt.
Chirurgische, Baumwoll-, Mode- oder Aktivkohlemasken erhöhten alle das Inhalationsrisiko im Einatmen von Fremdstoffen wie das selten berichtete Risiko des Einatmens von Mikroplastik aus Masken.
Mikroplastik ist nicht nur ein Gesundheitsrisiko, sondern auch eine Umweltkatastrophe. Jeden Monat werden etwa 129 Milliarden Einwegmasken weggeworfen. Jede von ihnen setzt täglich bis zu 173’000 Mikrofasern in den Meeren frei. Eine Umweltkatastrophe sondergleichen.
In folgenden Video sehen wir, wie die Maskierten, die zur ständigen Berichterstattung gezwungen werden, ihre Entscheidung rechtfertigen. «Vorsicht ist besser als Nachsicht», «Ich trage sie drinnen und draussen», und wiederholen damit die Aussagen der sozialen Medien. Kein Wunder, denn kritische Stimmen wurden komplett zum Schweigen gebracht.
Erwachsene, die sich für eine Maske entscheiden, sind eine Sache, aber Kinder zu quälen ist eine andere. Erlebe die Freude dieser Kinder, als sie erfahren, dass sie die Masken endlich ablegen können. Die psychologische Erleichterung ist deutlich spürbar.
Zusammenfassend lässt sich sagen, dass die Gesichtsmasken perfekt funktionierten: Sie dienten dazu, die Öffentlichkeit in Angst und Schrecken zu versetzen und zu manipulieren. Ähnlich wie beim Covid-PCR-Test hätte es ohne Masken keine Pandemie gegeben – sie dienten lediglich als tägliche Erinnerung an unsere angeblich tödliche Lage. Obwohl sich die so genannten Experten ständig selbst widersprachen, gab es keine Kritik von Journalisten oder Wissenschaftlern. Viele beugten sich dem Narrativ, weil sie entweder Opfer der psychologischen Operation wurden oder ihre Karriere nicht riskieren wollten. Diejenigen, die es wagten, Widerspruch zu äussern, wurden zum Schweigen gebracht, diffamiert, angezeigt und aus dem Verkehr gezogen.
Ob es eine gründliche gesellschaftliche Abrechnung geben wird oder ob die Gesellschaft Covid vergessen wird, während die nächste psychologische Operation, die Klimakrise, bevorsteht, bleibt unklar. Immer mehr der so genannten Experten, seien es Drosten, Walensky oder Fauci, ziehen sich aus der Öffentlichkeit zurück. Sie müssen nur dann Konsequenzen fürchten, wenn wir weiterhin Druck ausüben und uns weigern, ihr Handeln zu vergessen. Das ist genau der Grund, warum ich dieses Posting geschrieben habe. Wir müssen uns täglich an diese Verbrechen gegen die Menschlichkeit erinnern und so lange mit dem Finger auf die Schuldigen zeigen, bis die Justiz sich der Sache annimmt. Andernfalls wird das Gleiche unter dem Deckmantel des Klimas passieren, aber auf einer ganz anderen, dystopischen Ebene. Sozialpunkte, Kohlenstoffgutschriften, 15-Minuten-Städte, Fleisch- und Reisebeschränkungen und digitale Währungen sind auf dem Weg.

«Dravens Tales from the Crypt» bezaubert seit über 15 Jahren mit einer geschmacklosen Mischung aus Humor, seriösem Journalismus – aus aktuellem Anlass und unausgewogener Berichterstattung der Presse Politik – und Zombies, garniert mit jeder Menge Kunst, Entertainment und Punkrock. Draven hat aus seinem Hobby eine beliebte Marke gemacht, welche sich nicht einordnen lässt.








